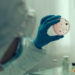
В Молдове предупредили о риске холеры после катастрофы на Каховской ГЭС

Вблизи села Кожушна Страшенского района 15 июня столкнулись микроавтобус, перевозивший рабочих завода, и автомобиль. В результате ДТП погиб один человек. Об этом сообщили в Генинспекторате полиции, пишет newsmaker.md.
Прибыв на место происшествия полиция установила, что столкновение произошло между микроавтобусом Volkswagen, перевозившим рабочих завода, и автомобилем Volvo.
В результате ДТП 60-летний пассажир микроавтобуса погиб на месте, а еще 9 человек доставили в районную больницу Страшен.
Оба водителя прошли тест на алкоголь с помощью аппарата Drager. Результаты теста в обоих случаях оказались отрицательными.
Полицейские устанавливают все обстоятельства аварии.